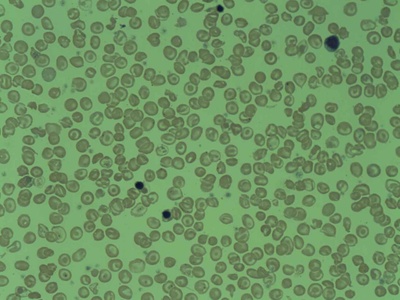
Beta-thalassemia

Genetic conditions affect people in every community and at every stage of life, influencing diagnosis, treatment options, and family planning. A short, organized overview can help readers quickly compare causes, inheritance patterns, and how common each condition is.
There are 20 Examples of Genetic Diseases, ranging from 22q11.2 deletion syndrome to Type 2 diabetes. For each entry the data are organized as Inheritance,Gene/chromosome,Prevalence (per 100,000); you’ll find below.
How reliable are the prevalence numbers and why do they vary?
Prevalence estimates come from population studies, registries and clinical reports, so they vary with screening practices, diagnostic criteria and local genetics services. Many conditions are underdiagnosed or reclassified as testing improves, so treat figures as approximations and check recent literature or databases for updates.
How should I read the Inheritance and Gene/chromosome columns?
“Inheritance” indicates how a condition is passed (e.g., autosomal dominant, recessive, X-linked), while “Gene/chromosome” points to the implicated locus or deletion. Together they help assess familial risk, but a genetic counselor or clinician can interpret personal implications and testing options.
Examples of Genetic Diseases
| Name | Inheritance | Gene/chromosome | Prevalence (per 100,000) |
|---|---|---|---|
| Down syndrome | Chromosomal | Chromosome 21 (trisomy 21) | 143 |
| Cystic fibrosis | Autosomal recessive | CFTR | 10 |
| Sickle cell disease | Autosomal recessive | HBB | Varies |
| Huntington disease | Autosomal dominant | HTT | 7 |
| Duchenne muscular dystrophy | X-linked recessive | DMD | 2-5 |
| Hemophilia A | X-linked recessive | F8 | Varies |
| Phenylketonuria (PKU) | Autosomal recessive | PAH | 6 |
| Tay-Sachs disease | Autosomal recessive | HEXA | Varies |
| Beta-thalassemia | Autosomal recessive | HBB | Varies |
| Marfan syndrome | Autosomal dominant | FBN1 | 20 |
| Fragile X syndrome | X-linked (repeat expansion) | FMR1 | 6 |
| Achondroplasia | Autosomal dominant | FGFR3 | 25 |
| Leber hereditary optic neuropathy (LHON) | Mitochondrial | MT-ND4, MT-ND1, MT-ND6 | 3 |
| Klinefelter syndrome | Chromosomal | 47,XXY | 200 |
| Turner syndrome | Chromosomal | 45,X | 40 |
| 22q11.2 deletion syndrome | Chromosomal microdeletion | 22q11.2 | 25 |
| Familial hypercholesterolemia | Autosomal dominant | LDLR, APOB, PCSK9 | 400 |
| Hereditary breast and ovarian cancer | Autosomal dominant | BRCA1, BRCA2 | 250 |
| Alzheimer disease (familial and late-onset) | Multifactorial/single-gene for familial | APP, PSEN1, PSEN2, APOE | Varies (age-dependent) |
| Type 2 diabetes | Multifactorial | TCF7L2 and many genes | 10,500 |
Images and Descriptions

Down syndrome
Down syndrome is a chromosomal condition from an extra chromosome 21 (trisomy 21), causing developmental delay, characteristic facial features and health issues. It is commonly diagnosed at birth (about 143 per 100,000) and severity varies widely.

Cystic fibrosis
Cystic fibrosis is an autosomal recessive disorder caused by CFTR mutations, affecting the lungs, pancreas and other organs. It leads to chronic infections and digestive problems; common in many populations (about 10 per 100,000) with variable severity and improved outcomes with therapy.

Sickle cell disease
Sickle cell disease is due to HBB mutations producing abnormal hemoglobin, causing pain crises, anemia and organ damage. Inheritance is autosomal recessive; prevalence varies by region and ancestry, often higher in people of African descent, with wide variability in severity.

Huntington disease
Huntington disease is an autosomal dominant neurodegenerative condition caused by CAG repeat expansion in HTT. It causes movement problems, cognitive decline and psychiatric symptoms; onset is typically in adulthood, progressive and relatively rare (about 7 per 100,000).

Duchenne muscular dystrophy
Duchenne muscular dystrophy is an X-linked disorder from DMD mutations causing progressive muscle weakness beginning in childhood. Boys are primarily affected, lose ambulation in adolescence, and face cardiac/respiratory complications; population prevalence is rare (about 2-5 per 100,000).

Hemophilia A
Hemophilia A is caused by pathogenic variants in F8 leading to low factor VIII and a lifelong bleeding tendency. It is X-linked and typically identified in childhood; severity ranges from mild to severe, and prevalence varies with population and diagnostic practices.

Phenylketonuria (PKU)
PKU is an autosomal recessive metabolic disorder caused by PAH mutations that prevent normal breakdown of phenylalanine, risking intellectual disability if untreated. Newborn screening and dietary management prevent damage; prevalence varies but is about 6 per 100,000 in many countries.

Tay-Sachs disease
Tay-Sachs is an autosomal recessive neurodegenerative disease caused by HEXA deficiency, leading to progressive brain damage and early death in the infantile form. Carrier frequency is higher in some groups; overall prevalence is rare and varies by population.
Beta-thalassemia
Beta-thalassemia results from HBB mutations reducing beta-globin production, causing anemia that ranges from mild to transfusion-dependent disease. Inheritance is autosomal recessive; prevalence varies widely by region, highest in Mediterranean, Middle Eastern and South Asian populations.

Marfan syndrome
Marfan syndrome is an autosomal dominant connective tissue disorder most often caused by FBN1 variants, affecting the skeleton, eyes and cardiovascular system. It raises risk of aortic aneurysm; prevalence is about 20 per 100,000 and severity varies among individuals.

Fragile X syndrome
Fragile X syndrome is caused by CGG repeat expansion in FMR1 and is the most common inherited cause of intellectual disability. It shows X-linked inheritance with variable expression, behavioral features and learning difficulties; prevalence is around 6 per 100,000 overall.

Achondroplasia
Achondroplasia is an autosomal dominant skeletal dysplasia usually caused by a recurrent FGFR3 mutation, producing short stature with characteristic limb proportions. It is typically evident at birth, often results from a de novo mutation, and has a prevalence near 25 per 100,000.

Leber hereditary optic neuropathy (LHON)
LHON is a mitochondrial disorder caused by pathogenic variants in mtDNA genes such as MT-ND4, leading to sudden central vision loss in young adults. Maternal inheritance is typical; overall prevalence is rare (about 3 per 100,000) with variable penetrance.

Klinefelter syndrome
Klinefelter syndrome (47,XXY) is a chromosomal condition in males that can cause taller stature, hypogonadism, learning differences and fertility issues. It is often underdiagnosed; prevalence is about 200 per 100,000 males (1 in 500), with variable clinical features.

Turner syndrome
Turner syndrome (45,X) affects females and causes short stature, ovarian insufficiency and possible heart or kidney differences. It is typically diagnosed in childhood or adolescence; prevalence is about 40 per 100,000 females (1 in 2,500 births) and features vary widely.

22q11.2 deletion syndrome
22q11.2 deletion syndrome (DiGeorge) is caused by deletion of a small region on chromosome 22, leading to heart defects, immune problems, palate differences and developmental issues. Clinical features are highly variable; prevalence is about 25 per 100,000.

Familial hypercholesterolemia
Familial hypercholesterolemia is an autosomal dominant disorder most often due to LDLR, APOB or PCSK9 variants, causing very high LDL cholesterol and early coronary artery disease. Heterozygous FH is common (~400 per 100,000, 1 in 250) and highly treatable.

Hereditary breast and ovarian cancer
Hereditary breast and ovarian cancer syndrome is primarily due to pathogenic variants in BRCA1 or BRCA2, greatly increasing lifetime breast and ovarian cancer risk. Inheritance is autosomal dominant; pathogenic variant prevalence is about 250 per 100,000 (1 in 400), higher in some groups.

Alzheimer disease (familial and late-onset)
Alzheimer disease is a neurodegenerative dementia with complex genetics: rare early-onset familial forms are autosomal dominant (APP, PSEN1, PSEN2), while late-onset disease is multifactorial with major risk alleles like APOE. Prevalence strongly increases with age.

Type 2 diabetes
Type 2 diabetes is a common multifactorial metabolic disease influenced by many genes (e.g., TCF7L2) and lifestyle factors, causing high blood sugar and long-term vascular complications. Prevalence is high in many countries (about 10,500 per 100,000) and rises with age.









